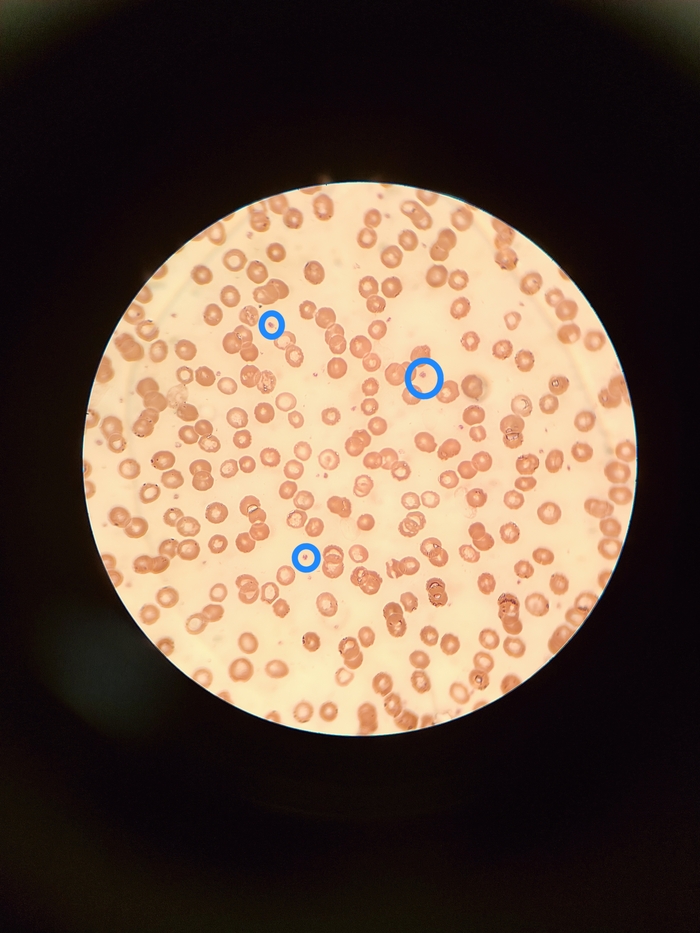

"Учите биологию и анатомию правильно!" или обзор аниме-сериала "Клетки за работой!"
Приветствую. Настроения нет, сразу к делу.
Учите биологию и анатомию. Я в своё время не учил ни тот ни другой предмет. И теперь жалею, потому что разобраться в том что такое эритроцит и лейкоцит не могу. Но всегда помогает интернет, а в данном случае - аниме.
"Клетки за работой" скорее всего вам известен тайтл, но думаю найдутся те кто с удивлением скажут: такое тоже японцы сняли? Да, и они не просто сняли историю о девушке-эритроците, что спасла целый организм.
В любом случае кто хочет оставайтесь и читайте стену текста. А я начну.
*Эритроцит AE 3803 прямо мечта любого мужчины!*
Что такое "Клетки за работой"? Одни называют это "вот это бред сняли японцы, я фигею" другие отзываются восторженно "класс, вот бы такое в школе показывали на уроках биологии". Я же скажу так: у каждого своё. Если вы не любите биологию со школы, то данный сериал смотреть не стоит. Если же вы любили биологию, или обожаете анатомию человека, то 100% стоит запустить и посмотреть серии. Тем более идут они недолго.
В чём же заключается сюжет сериала? Фактически это антропоморфизм, то есть персонажами выступают человекоподобные существа. Например в данном случае - клетки.
Действия происходят в мире клеток, то есть человеческом организме. Там всё обставлено так: есть сердце, желудок, лёгкие, кишечник и прочие органы. Основной сюжет строится на лейкоцитах, что доставляют воздух и помогают нашему организму нормально фукнционировать. Конкретно главная героиня это Эритроцит AE 3803. Она молода, наивна, но очень трудолюбива. Потому часто пугает дорогу, не успевает вовремя, и всё же с каждым днём проходит через настоящие испытания. Благо у неё есть наставник
Теперь конкретно сюжет делится на две части. В первой части ГГ в каждой серии перемещается от одного органа к другому, попадая в сложные ситуации. Это может быть: нападения бактерий, грипп, сложность в доставке кислорода через тесные ряды и многое другое. Фактически задача создателей аниме- показать на примере аниме, как работает человеческий организм.
Вторая часть это взаимодействие с другими клетками. Это могут быть макрофаги, спецнааааз ой то есть T-киллер, тромбоцитики, тучная клетка, базофил, NK-клетка и так далее. Но самое главное - лейкоцит, с которым идёт активный "шиппинг" по версии фанатов
Интересен ли сюжет? Да, потому что каждая серия это новый вызов. Рак, нападения золотистого стафилакока, или даже ранение организма показывается не просто выдумано, а научно. Описывается процесс голосом рассказчика, и это интересно. Но всё же больше я хочу уделить зрелищности, ибо там есть о чём рассказать.
*Каждый раз новая история, новые персонажи, и философия*
Данный аспект нужно поделить на части. Потому приготовьтесь, будет много писанины.
Юмор. В аниме много юмора. Чаще всего он связан с профессиональной темой, то есть о том как ведут себя клетки. Чаще всего улыбаться предстоит не потому что так требует аниме, а потому что вы видите клетки такие же как и люди: им нужно отдыхать, развлекаться, прикалываться, и так далее. Я не буду вставлять сюда фрагменты, так как это уже спойлер, но поверьте- в каждой серии кроме серьёзности и медицинских терминов есть где посмеяться!
2.Персонажи. Каждый персонаж, то есть клетка - очеловечен. Они злятся, радуются, строят отношения с другими клетками, рассуждают справедливо. Для примера я приведу моих любимых персонажей. Вот это чтобы понимали - макрофаги. Вроде и горничные, но когда берут оружие в руки то превращаются в настоящих убийц.
Вот так представили T-Киллера. Такой серьёзный мужик, что убивает микробов и чаще всего выходит из себя когда с ним рядом NK-клетка
Вот так выглядит тучная клетка. Такая леди за работой вся
И так далее. По сути каждый персонаж, каждая клетка очеловечена и это выглядит странно. Но зато отлично раскрывает их характер, задачи и то что многие воспринимают как "данность". Ну есть клетки в моём теле и есть, чё бубнеть? А нет, вам стоит знать в лицо тех, кто обеспечивает ваш организм всем необходимым.
3. Медицинский подход к обучению зрителя. То есть вам не только показывают клетки и делают смешные моменты, но и рассказывают как устроен тот или иной процесс. Или какие болезни вызывает "золотистый стафилакокк", или что бывает при ранение тела? Каждая серия это новая ситуация, а потому задача создателей аниме показать вам что же на самом деле бывает, когда вы себя плохо чувствуете. Фактически это база, которая и держит планку аниме.
4. Битвы. Что думаете тут только разговоры, ходьба и медицинские термины? Неа, тут ещё есть очень крутые сражения, когда прямо наполнены анализом противника и многое другое. Правда иногда бывает вот так, но это ведь тоже интересно! Кроме того враги то есть микробы и бактерии имеют свой характер и даже цели. Чего стоит "дединсайд" раковая клетка.
5. Тромбоцитики. Я не убедил вас смотреть? Точно? Тогда предлагаю посмотреть одно видео. Честно его и всё, а дальше сами решите интересно ли вам такое аниме или нет. Что же, представляю вам тромбоцитиков.
Ну какие же они милааашки.
Если подвести итог то выходит следующее: сочетание отличного сюжета спроецированного на том как работает наш организм, отличные персонажи созданные из реальных клеток, юмор и диалоги, медицинские термины и возможность увидеть как работает та или иная клетка. К этому ещё можно добавить финал, который потрясёт до глубины души.
А и остался опенинг, всё таки важно его добавить
*Общий итог*
Клетки за работой - аниме, на которое стоит потратить время. Оно может быть просмотрено просто для ознакомления с биологией, или для подготовки к медицинским экзаменам. В любом случае рекомендую!
Спасибо за внимание!
Желаю всем хорошего настроения и такого же аниме!